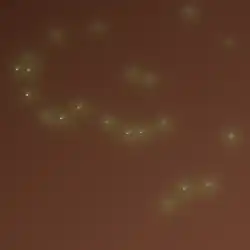

Шоколадный агар

Шокола́дный ага́р (устар. агар с гретой кровью) — представляет собой питательную среду, обогащённую лизированной высокой температурой кровью или гемоглобином, которая применяется для выделения и культивирования патогенных бактерий с высокими питательными потребностями[1][2]. Питательная среда получила название за характерный цвет и не содержит в своём составе шоколад или какао. Условно шоколадный агар можно назвать разновидностью кровяного агара, однако эти среды различаются по назначению и способу приготовления.
Состав и приготовление
В качестве основы шоколадного агара используют широкий спектр плотных питательных сред, применяемых в микробиологии[3]. К расплавленной стерильной основе добавляют 5-10 % крови животных и прогревают на водяной бане при температуре около 80 °C в течение 5 минут, для того чтобы лизировать эритроциты и инактивировать ферменты, разрушающие фактор роста V. В некоторых случаях, например при использовании крови свиней или коз, температура прогревания может составлять 100 °C, а время прогревания увеличивают до 15 минут[4].
Зачастую для приготовления шоколадного агара вместо крови используют стерилизованную в автоклаве суспензию, приготовленную из сухого гемоглобина. В связи с тем, что гемоглобин не является полноценной заменой крови, в питательную среду добавляют синтетические ростовые добавки, содержащие НАД, необходимый для роста бактерий рода Haemophilus, а также витамины и вещества, стимулирующие рост гонококков и менингококков[3][5].
Применение
Шоколадный агар используют для выращивания требовательных к питательной среде бактерий, таких как гонококк (Neisseria gonorrhoeae) и менингококк (Neisseria meningitidis)[6]. Кроме того, некоторые патогенные бактерии (в частности, Haemophilus influenzae) нуждаются в дополнительных факторах роста V и X[7], которые находятся внутри красных клеток крови (эритроцитов). Для успешного выращивания таких бактерий необходимы лизированные (разрушенные методом медленного нагревания) эритроциты. Температура в 80 °C также инактивирует ферменты, которые могли бы метаболизировать NAD (Никотинамидадениндинуклеотид).
В отличие от кровяного агара, при культивировании микроорганизмов на шоколадном агаре не происходит гемолиза. При этом, некоторые α- и β-гемолизирующие микроорганизмы, выделяющие перекись водорода, образуют на шоколадном агаре зоны позеленения, сходные с α-гемолизом[8].
Добавление бацитрацина к шоколадному агару делает его элективной питательной средой, избирательной для рода Haemophilus. Вариант шоколадного агара Thayer-Martin содержит целый ассортимент антибиотиков и является элективной питательной средой для культивирования различных видов грамотрицательных диплококков рода Neisseria.
См. также
Примечания
- ↑ Segen. Chocolate agar: Definition (англ.). The Free Dictionary. Дата обращения: 6 января 2015. Архивировано 15 ноября 2014 года.
- ↑ Anderson, Cindy. Great Adventures in the Microbiology Laboratory (англ.). — 7th. — Pearson, 2013. — P. 175. — ISBN 978-1-269-39068-2. (англ.)
- 1 2 Atlas, Ronald M.,. Handbook of microbiological media. — Taylor & Francis, 2010-01-01. — ISBN 9781439804087.
- ↑ Chandar Anand, Rhonda Gordon, Helene Shaw, Kevin Fonseca, Merle Olsen. Pig and Goat Blood as Substitutes for Sheep Blood in Blood-Supplemented Agar Media (англ.) // Journal of Clinical Microbiology. — 2000-02-01. — Vol. 38, iss. 2. — P. 591—594. — ISSN 0095-1137. Архивировано 2 сентября 2020 года.
- ↑ J. E. Martin, T. E. Billings, J. F. Hackney, J. D. Thayer. Primary isolation of N. gonorrhoeae with a new commercial medium // Public Health Reports. — 1967-04-01. — Т. 82, вып. 4. — С. 361—363. — ISSN 0094-6214.
- ↑ Gunn, B.A. Chocolate agar: A differential medium for gram positive cocci (англ.). PubMed. Дата обращения: 6 января 2015. Архивировано 15 февраля 2020 года.
- ↑ Bergey’s Manual of Systematic Bacteriology (англ.). Дата обращения: 3 октября 2017. Архивировано из оригинала 31 января 2010 года.
- ↑ Einar Leifson. Types of Bacteria on Blood and Chocolate Agar and the Immediate Cause of These Types (англ.) // American Society for Microbiology. — American Society for Microbiology, 1932. — Vol. 24, iss. 6. — P. 473—487. — ISSN 0021-9193.